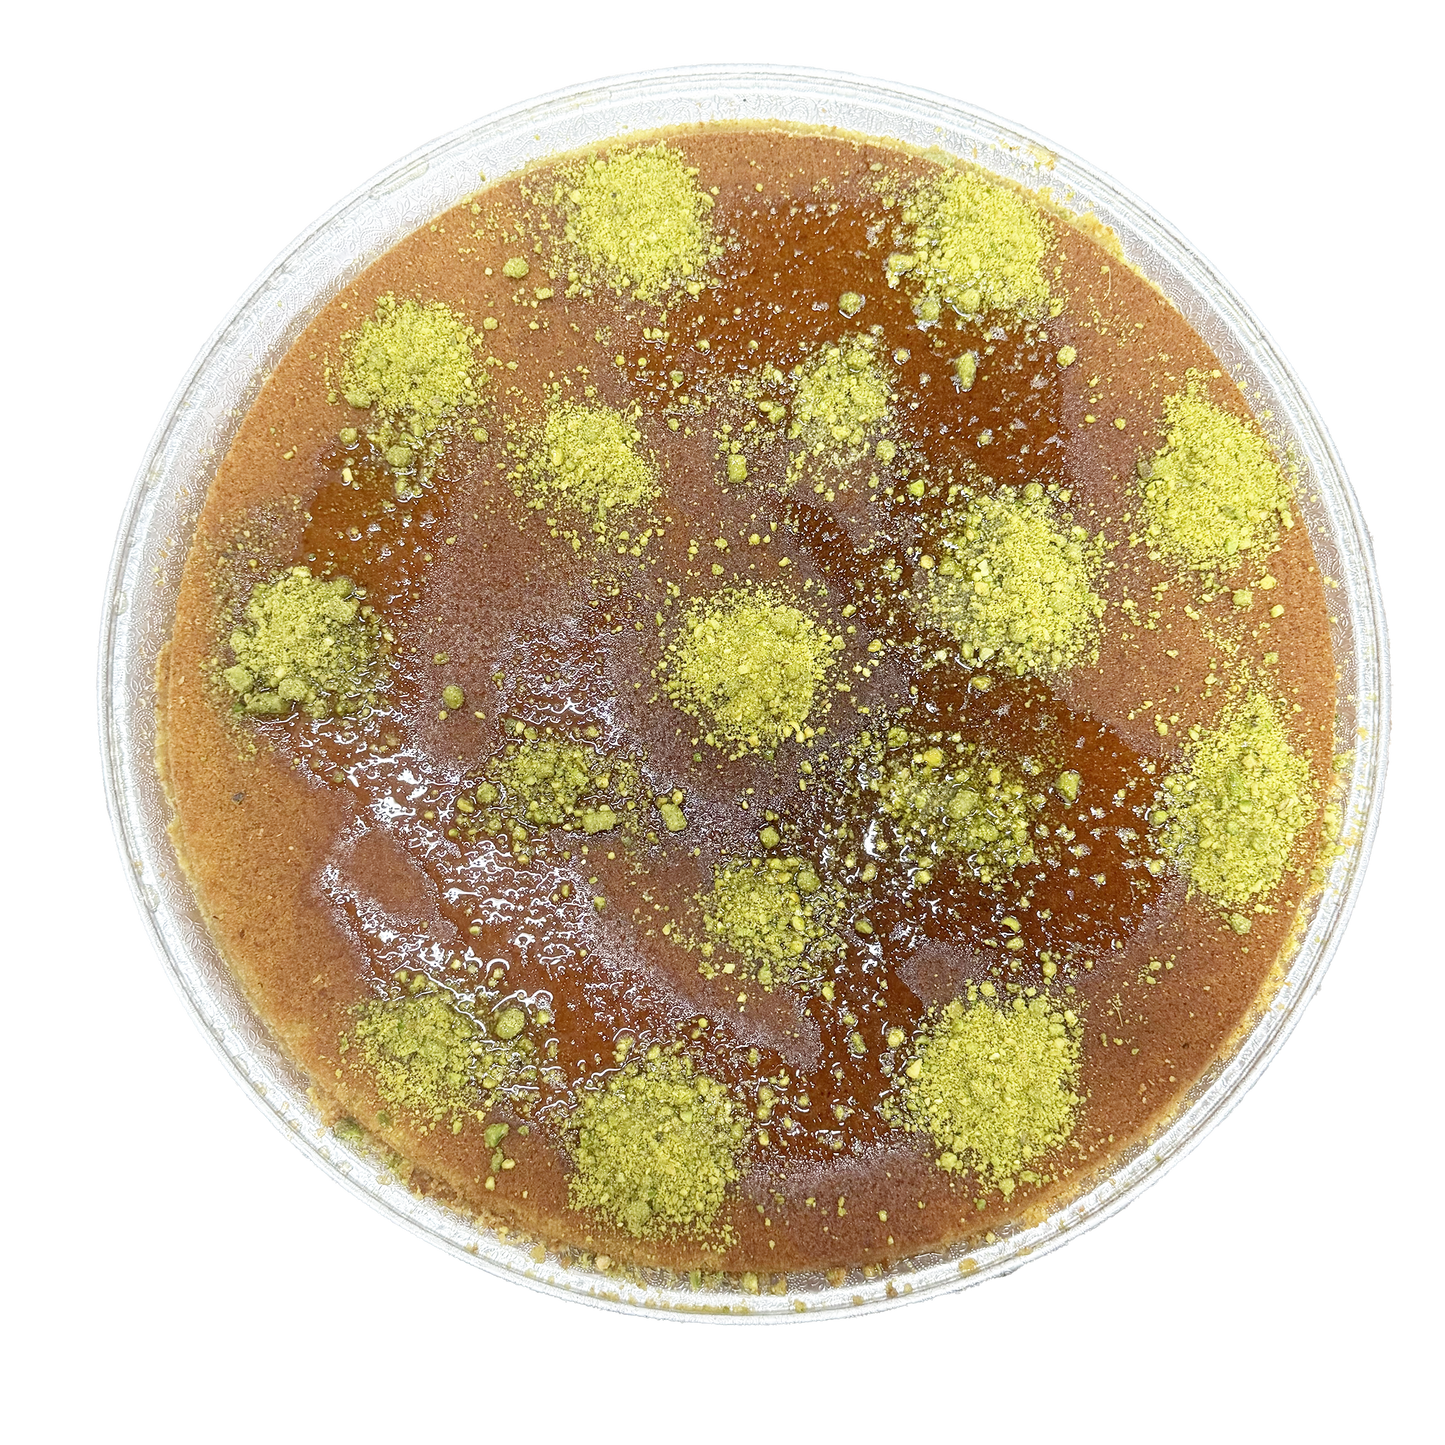
Large Knafeh Naameh Tray 18 Inch

Victory Sweets
Large Knafeh Naameh Tray 18 Inch
Large Knafeh Naameh Tray 18 Inch
- Quality Products
- Made Fresh To Order
- Secure payments
Couldn't load pickup availability
SHIPS FROZEN OR PICK UP WARM & READY
Knafeh Naameh – A Smooth and Sweet Middle Eastern Delight
Discover the delicate, smooth flavors of Knafeh Naameh, a traditional Middle Eastern dessert that is loved for its fine, tender texture and sweet, cheesy filling. Unlike its crispy counterpart (Knafeh Khishneh), Knafeh Naameh is made with finely ground semolina dough, giving it a soft, velvety finish that melts in your mouth. This dessert is generously filled with rich, stretchy cheese and topped with a fragrant syrup infused with rose water, offering a perfect balance of sweetness and subtle floral notes.
Our Knafeh Naameh is freshly handcrafted using premium ingredients to bring you an authentic taste of this beloved Middle Eastern classic. Whether you’re celebrating a special occasion or simply indulging in a sweet treat, Knafeh Naameh delivers an unforgettable experience with every bite.
Key Features:
- Authentic Middle Eastern Recipe: Made with finely ground semolina dough for a soft, tender texture that’s different from the crispiness of Knafeh Khishneh.
- Sweet Cheese Filling: Filled with layers of rich, melted cheese that perfectly balances the sweetness of the syrup.
- Fragrant Syrup: Drizzled with syrup infused with rose water for a delicate floral flavor.
- Perfect for Special Occasions: Ideal for sharing with friends and family during holidays, gatherings, or as an indulgent dessert.
Ingredients:
- Finely ground semolina dough
- Sweet cheese (such as Nabulsi or Akkawi)
- Butter
- Sugar
- rose water
Why Choose Our Knafeh Naameh?
- Made Fresh Daily: We craft our Knafeh Naameh fresh, using only the highest-quality ingredients to ensure maximum flavor and authenticity.
- Delicate and Smooth Texture: Unlike crispy Knafeh varieties, Knafeh Naameh features a soft, velvety texture that melts in your mouth.
- Traditional Flavors: Experience the rich heritage of the Middle East with every bite of our carefully prepared Knafeh Naameh.
Serving Suggestions:
Knafeh Naameh is best enjoyed warm. Reheat it in the oven to melt the cheese and allow the syrup to soak into the soft dough, creating a rich, gooey texture. Garnish with crushed pistachios or serve with a scoop of vanilla ice cream for an extra indulgent treat.
Order your Knafeh Naameh today and experience the rich flavors and smooth textures of one of the Middle East's most iconic desserts!
SHIPS FROZEN - IMPORTANT: This is a NEXT DAY AIR item ONLY.
Same day shipping for orders placed by 3PM PACIFIC Time.